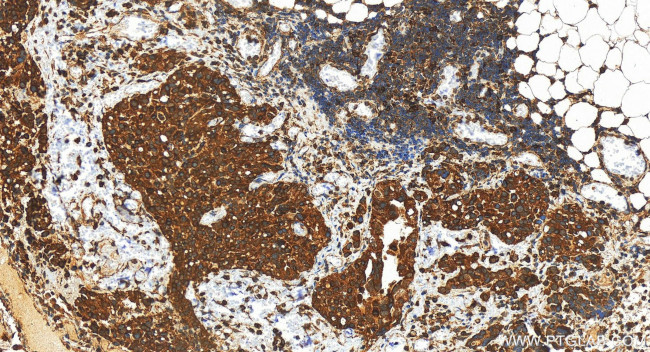
UNC93B1 Antibody in Immunohistochemistry (Paraffin) (IHC (P))

Search
Proteintech
UNC93B1 Polyclonal Antibody
{{$productOrderCtrl.translations['antibody.pdp.commerceCard.promotion.promotions']}}
{{$productOrderCtrl.translations['antibody.pdp.commerceCard.promotion.viewpromo']}}
{{$productOrderCtrl.translations['antibody.pdp.commerceCard.promotion.promocode']}}: {{promo.promoCode}} {{promo.promoTitle}} {{promo.promoDescription}}. {{$productOrderCtrl.translations['antibody.pdp.commerceCard.promotion.learnmore']}}
产品信息
28359-1-AP
种属反应
宿主/亚型
分类
类型
抗原
偶联物
形式
浓度
规格
纯化类型
保存液
内含物
保存条件
运输条件
产品详细信息
Immunogen sequence: MEAEPPLYPM AGAAGPQGDE DLLGVPDGPE APLDELVGAY PNYNEEEEER RYYRRKRLGV LKNVLAASAG GMLTYGVYLG LLQMQLILHY DETYREVKYG NMGLPDIDS
靶标信息
The endoplasmic reticulum (ER) protein Unc93b, a human homolog of the C. elegans Unc93 gene, was initially identified by a forward genetic screen using N-ethyl-N-nitrosourea where a histidine-to-arginine substitution in Unc93b caused defects in Toll-like receptor (TLR) 3, 7 and 9 signaling. Unlike Unc93a, another homolog of the C. elegans Unc93 gene whose function is unknown, Unc93b specifically interacts with TLR3, 7 and 9; the histidine-to-arginine point mutation used to identify Unc93b abolishes this interaction. Mice carrying this point mutation are highly susceptible to infection with a number of viruses, indicating that Unc93b plays an important role in innate immunity.
仅用于科研。不用于诊断过程。未经明确授权不得转售。
篇参考文献 (0)
生物信息学
蛋白别名: hUNC93B1; Protein unc-93 homolog B1; unc-93 homolog B; unc-93 homolog B1; unc-93 related protein; Unc-93B1; unc93 homolog B; unc93 homolog B1
基因别名: IIAE1; Unc-93B1; UNC93; UNC93B; UNC93B1
UniProt ID: (Human) Q9H1C4, (Mouse) Q8VCW4
Entrez Gene ID: (Human) 81622, (Pig) 100522238, (Rat) 361689, (Mouse) 54445